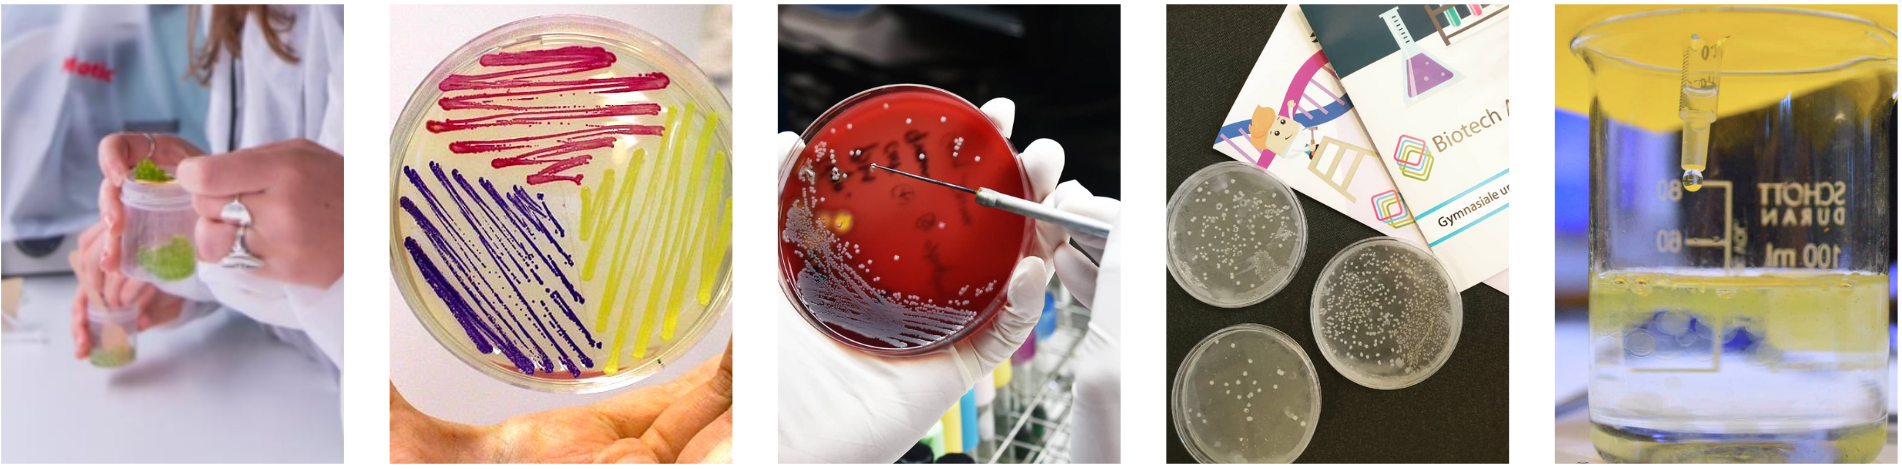

Lærer-guide til Biotech Academy
Biotech Academy tilbyder bioteknologisk undervisningsmateriale og /-redskaber til brug for primært de gymnasiale uddannelser og udskolingen i grundskolen. Fælles for alle vores undervisningstilbud er, at de er gratis og udviklet med henblik på at opfylde de faglige mål for udskolingen og/eller de gymnasiale bioteknologiske linjer.
Vores formål er at skabe kvalitetsundervisning og begejstring blandt unge omkring bioteknologi, biologi og kemi. Biotech Academy er non-profit, og materiale samt driften er finansieret af fonde. Den nuværende drift er finansieret af Novo Nordisk Fonden.
Forløb
Undervisningsforløbene på hjemmesiden udgør Biotech Academys DNA. Forløbene tager udgangspunkt i de faglige mål og perspektiverer ofte til nutidige problemstillinger, og inkorporerer ofte praktiske og interaktive øvelser i undervisningen. De er inddelt i grundskoleforløb og gymnasieforløb.
De fleste forløb er opbygget i blokke, bestående af teori og opsamlende opgaver. Efterfølgende blokke bygger herefter videre på den forudgående teori og opgave så der dannes et samlet overblik og perspektiv indenfor emnerne. Blokinddelingen skaber muligheder for, at du som lærer kan bruge hele forløbet eller blot inkorporere individuelle dele af forløbene i din egen undervisning.
For at finde et relevant forløb kan du orientere dig i forløbets forside for inspiration. Herefter kan du tilgå lærervejledningen hvor en oversigt over det faglige indhold samt øvelser findes.
Forsøgskits
Biotech Academy har en række af forsøg du kan bruge i din undervisning. Nogle af dem producerer vi selv materiale til og sender gratis (inklusive fragt) ud som forsøgskits efter online bestilling. Forsøgskitsene har tilhørende undervisningsmateriale, og kan fungere glimrende som en del af undervisningsforløbene. Forsøgskits kan bestilles på vores bestillingsportal (undtagen Biosensor). Du kan finde en oversigt over alle vores forsøg i vores forsøgsoversigt.
Algedråber og fotosyntese
Algeforsøget med fremstilling af algedråber giver eleverne et visuelt og praktisk eksempel på fotosyntesen. Som et led i forløbet “Den Grønne Revolution” vil eleverne opnå indsigt i havets vigtighed og muligheder – med specielt fokus på alger. Forsøget kan naturligvis bestilles og gennemføres i din undervisning uden brug af resten af forløbsmaterialet. Forsøget kan derudover bestilles individuelt til elever, som ønsker at bruge det i forbindelse med en stor opgave.
Algeforsøget er målrettet 7.-9. klasses niveau. Hvis du ønsker at lave det med din gymnasieklasse anbefaler vi at udnytte afsnittet om spektrofotometri. På den måde at øge sværhedsgraden til et passende niveau for eleverne. Forsøget tager ca. 1 time at udføre,hvor der efterfulgt er 2 timers ventetid på resultatet.
Biosensor
Biosensor-forsøgene er henvendt de gymnasiale uddannelser. Forsøgene benytter genmodificering (transformation) til at give flotte, visuelle resultater, og er på baggrund af feedback blevet designet til at kunne udføres på ét modul (90 minutter).
Forsøgene er godkendt til brug i gymnasielaboratorier, hvis man modtager en godkendelse fra fagkonsulenten. Bemærk, at underviseren selv skal have visse basale materialer og være trænet i GMO laboratorieteknikker. Der er to forskellige forsøgskits man kan bestille, case 1 og case 2, som er designet til at kunne gennmføres samtidigt eller hver for sig (uden at case 1 er forudgående for den anden).
Brødbagningsenzymer
Forsøget med brødbagningsenzymer er primært henvendt gymnasiet og er tilknyttet forløbet ’Enzymer og brødbagning’. Vi udsender tre slags enzymer (amylase, xylanase, peptidase), som tilsættes en brøddej og effekten af enzymerne observeres.
Pseudomonas fluorescens
Forsøget er primært henvendt gymnasiet og tilknyttet forløbet ’Fra Darwin til bioteknologi’. Den aerobe jordbakterie Pseudomonas fluorescens har den særlige egenskab at den hurtigt udvikler sig for at tilpasse sine omgivelser og at der kan opstå mutanter med en en anden morfologi i sine kolonier. Dette forsøg understøtter evolutionsteorien ved at man kan observere ændringer i P. Fluorescens stammen afhængigt af en påvirkning fra omgivelserne.
Biostriben
Biostriben er Biotech Academys filmhjørne og visuelle undervisningsinitiativ. Her dækkes emner med én eller flere korte og illustrerende undervisningsvideoer, der afdækker centrale begreber fra de faglige mål.
Du kan i grundskole-kategorien også vælge at sortere i ’Film’, som er inspirerende, let forståelige og visuelt flotte fortællinger om bioteknologiske fænomener.
Biowiki
Vores biowiki indeholder korte beskrivelser af grundlæggende begreber, fx protein, polaritet eller grønkorn, oftest med forklarende illustrationer. Biowikien er også ordbasen for de svære begreber der bliver brugt i forløbene. Her bruges Biowikien til understøttende forklaringer af disse.
Det Virtuelle Laboratorium
Det Virtuelle Laboratorium er en online laboratoriesimulator der er tiltænkt gymnasierne. Her kan dine elever udføre et af seks forskellige forsøg med værtktøjer du måske ikke har til rådighed i gymnasiet. Det er en spændende interaktiv læringsform, der, efterhånden som brugeren udfører laboratorieforsøg i simulatoren, visualiserer, hvad der sker på mikroskopisk niveau. Laboratoriet er browserbaseret, lettilgængeligt og du kan selv bestemme hvordan et virtuelt laboratorieforsøg skal understøtte din klasses undervisning.
Der er også flere gymnasieforløb, der inkorporerer forsøg i Det Virtuelle Laboratorie.
Biotech Academy Camp
Biotech Academy afholder hvert år en camp for motiverede 2. og 3.g elever, der udvælges på baggrund af ansøgninger. Formålet med campen er at tage unge med stor interesse for bioteknologi og spække dem med inspiration, oplevelser og værktøjer, der kan give dem et indblik i den bioteknologiske verden udenfor gymnasiet.
Campen varer hele efterårsferien og byder på masser af tid i laboratoriet, med omfattende forsøgsforløb der er skræddersyet til efterårsferien. Campen inddrager inspirerende events med f.eks. virksomhedsbesøg hos industriens store spillere og oplæg med forskere, professorer og iværksættere. Derudover er der også sociale elementer, hvor nye venskaber formes og eleverne når at nyde efterårsferien. Campen er gratis for deltagere inklusive forplejning og overnatning.